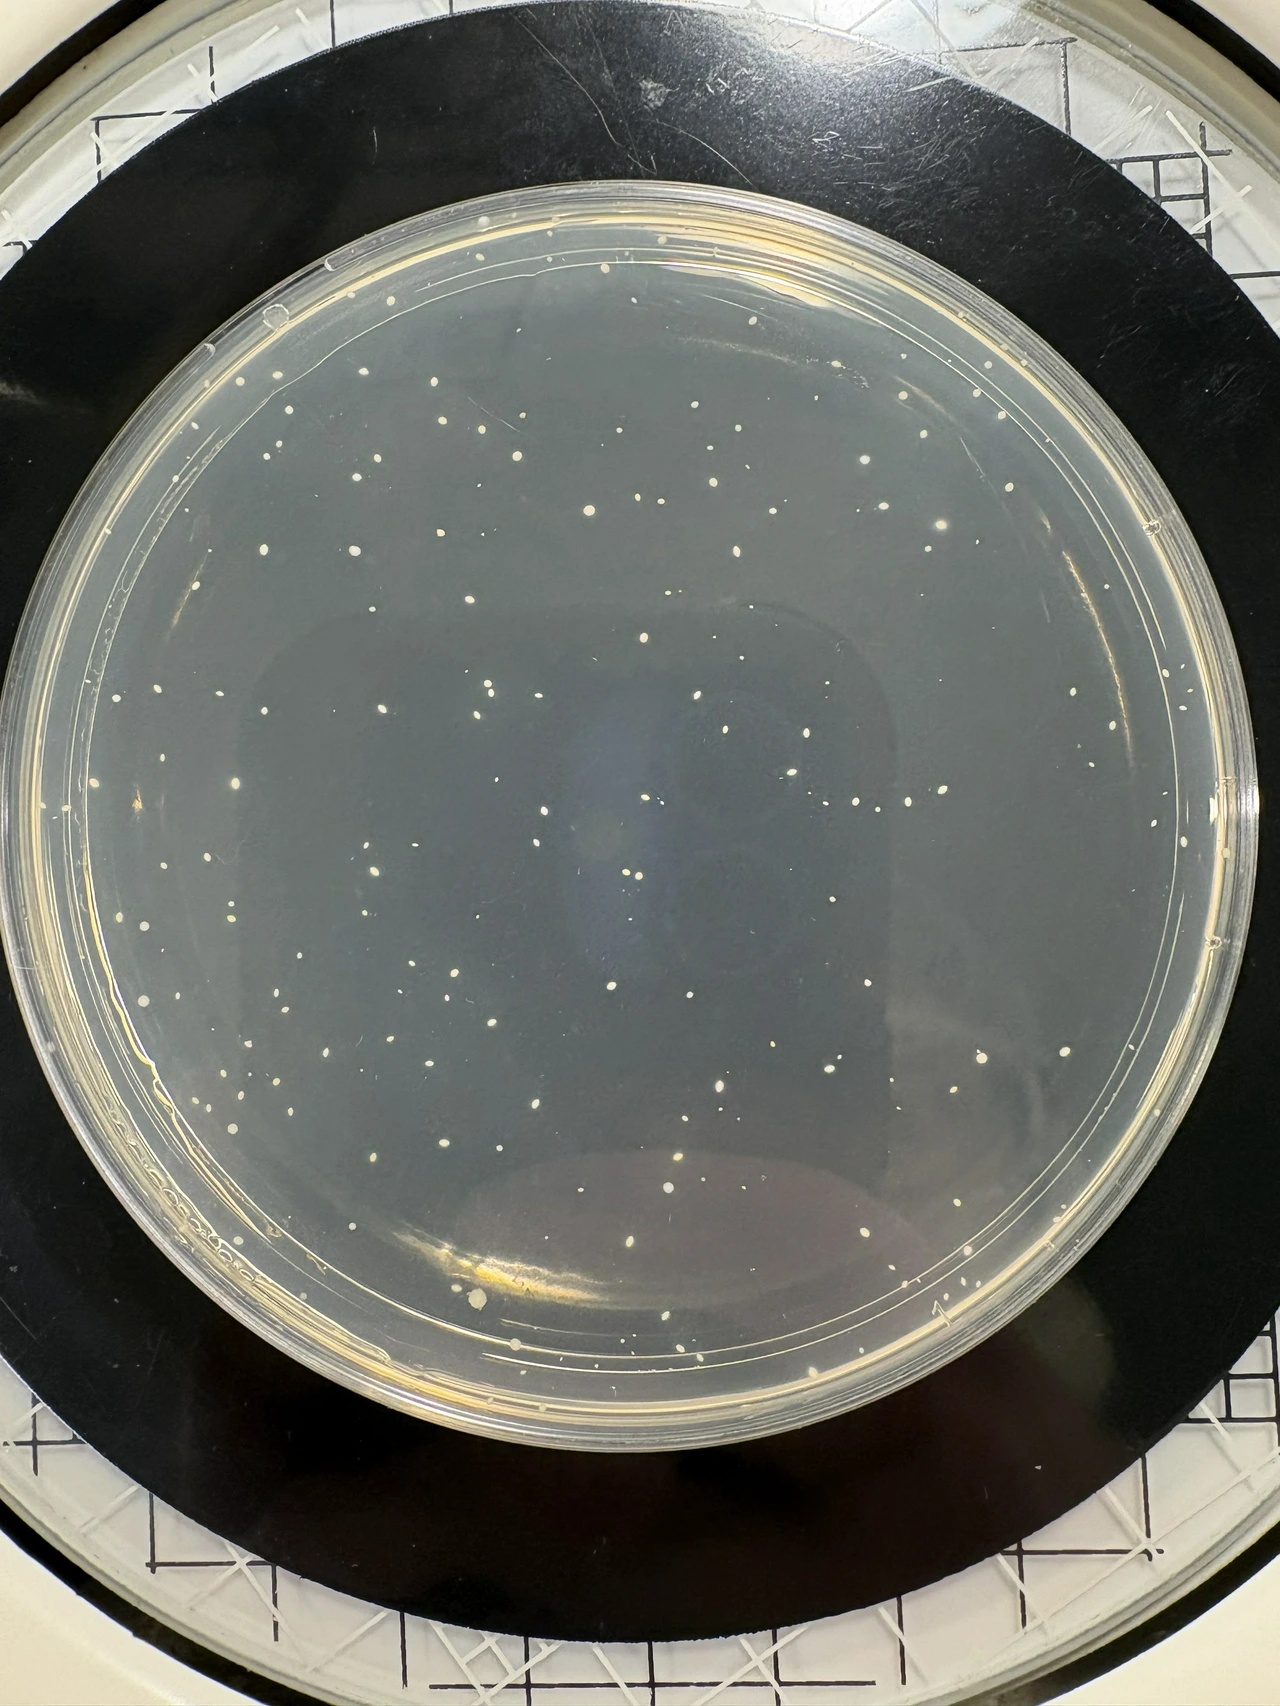
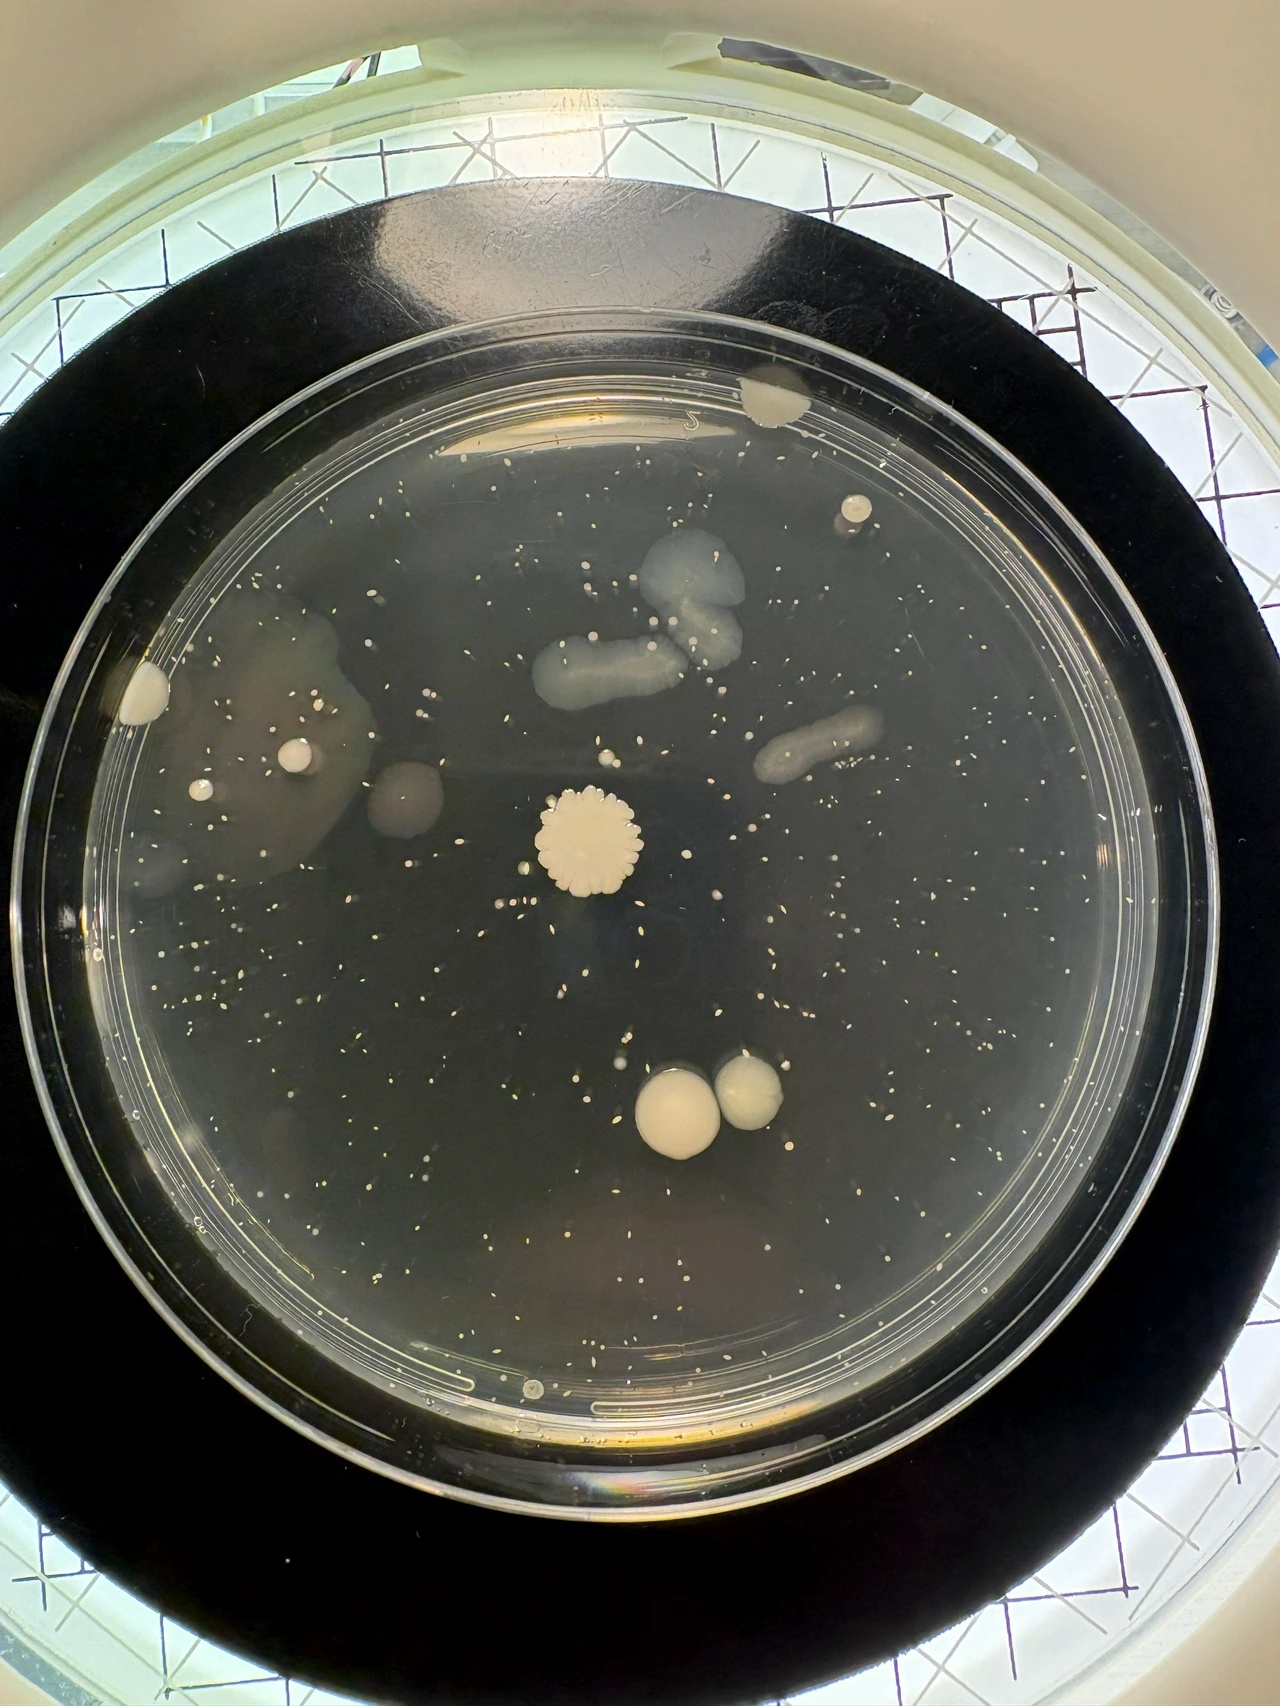
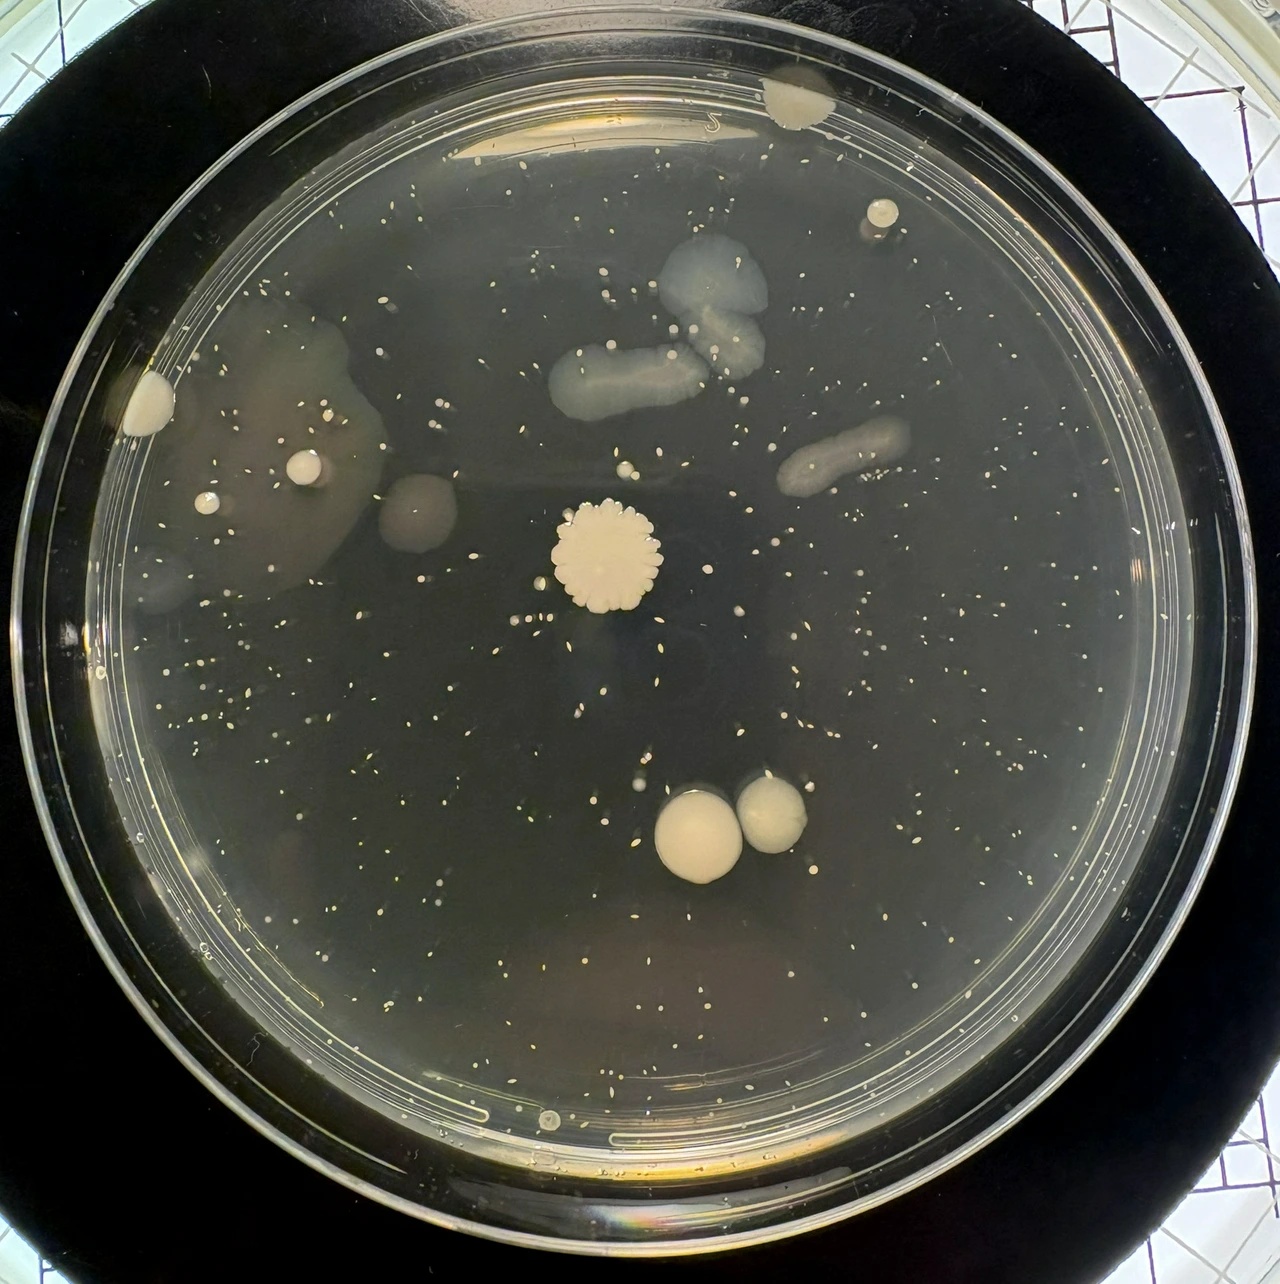
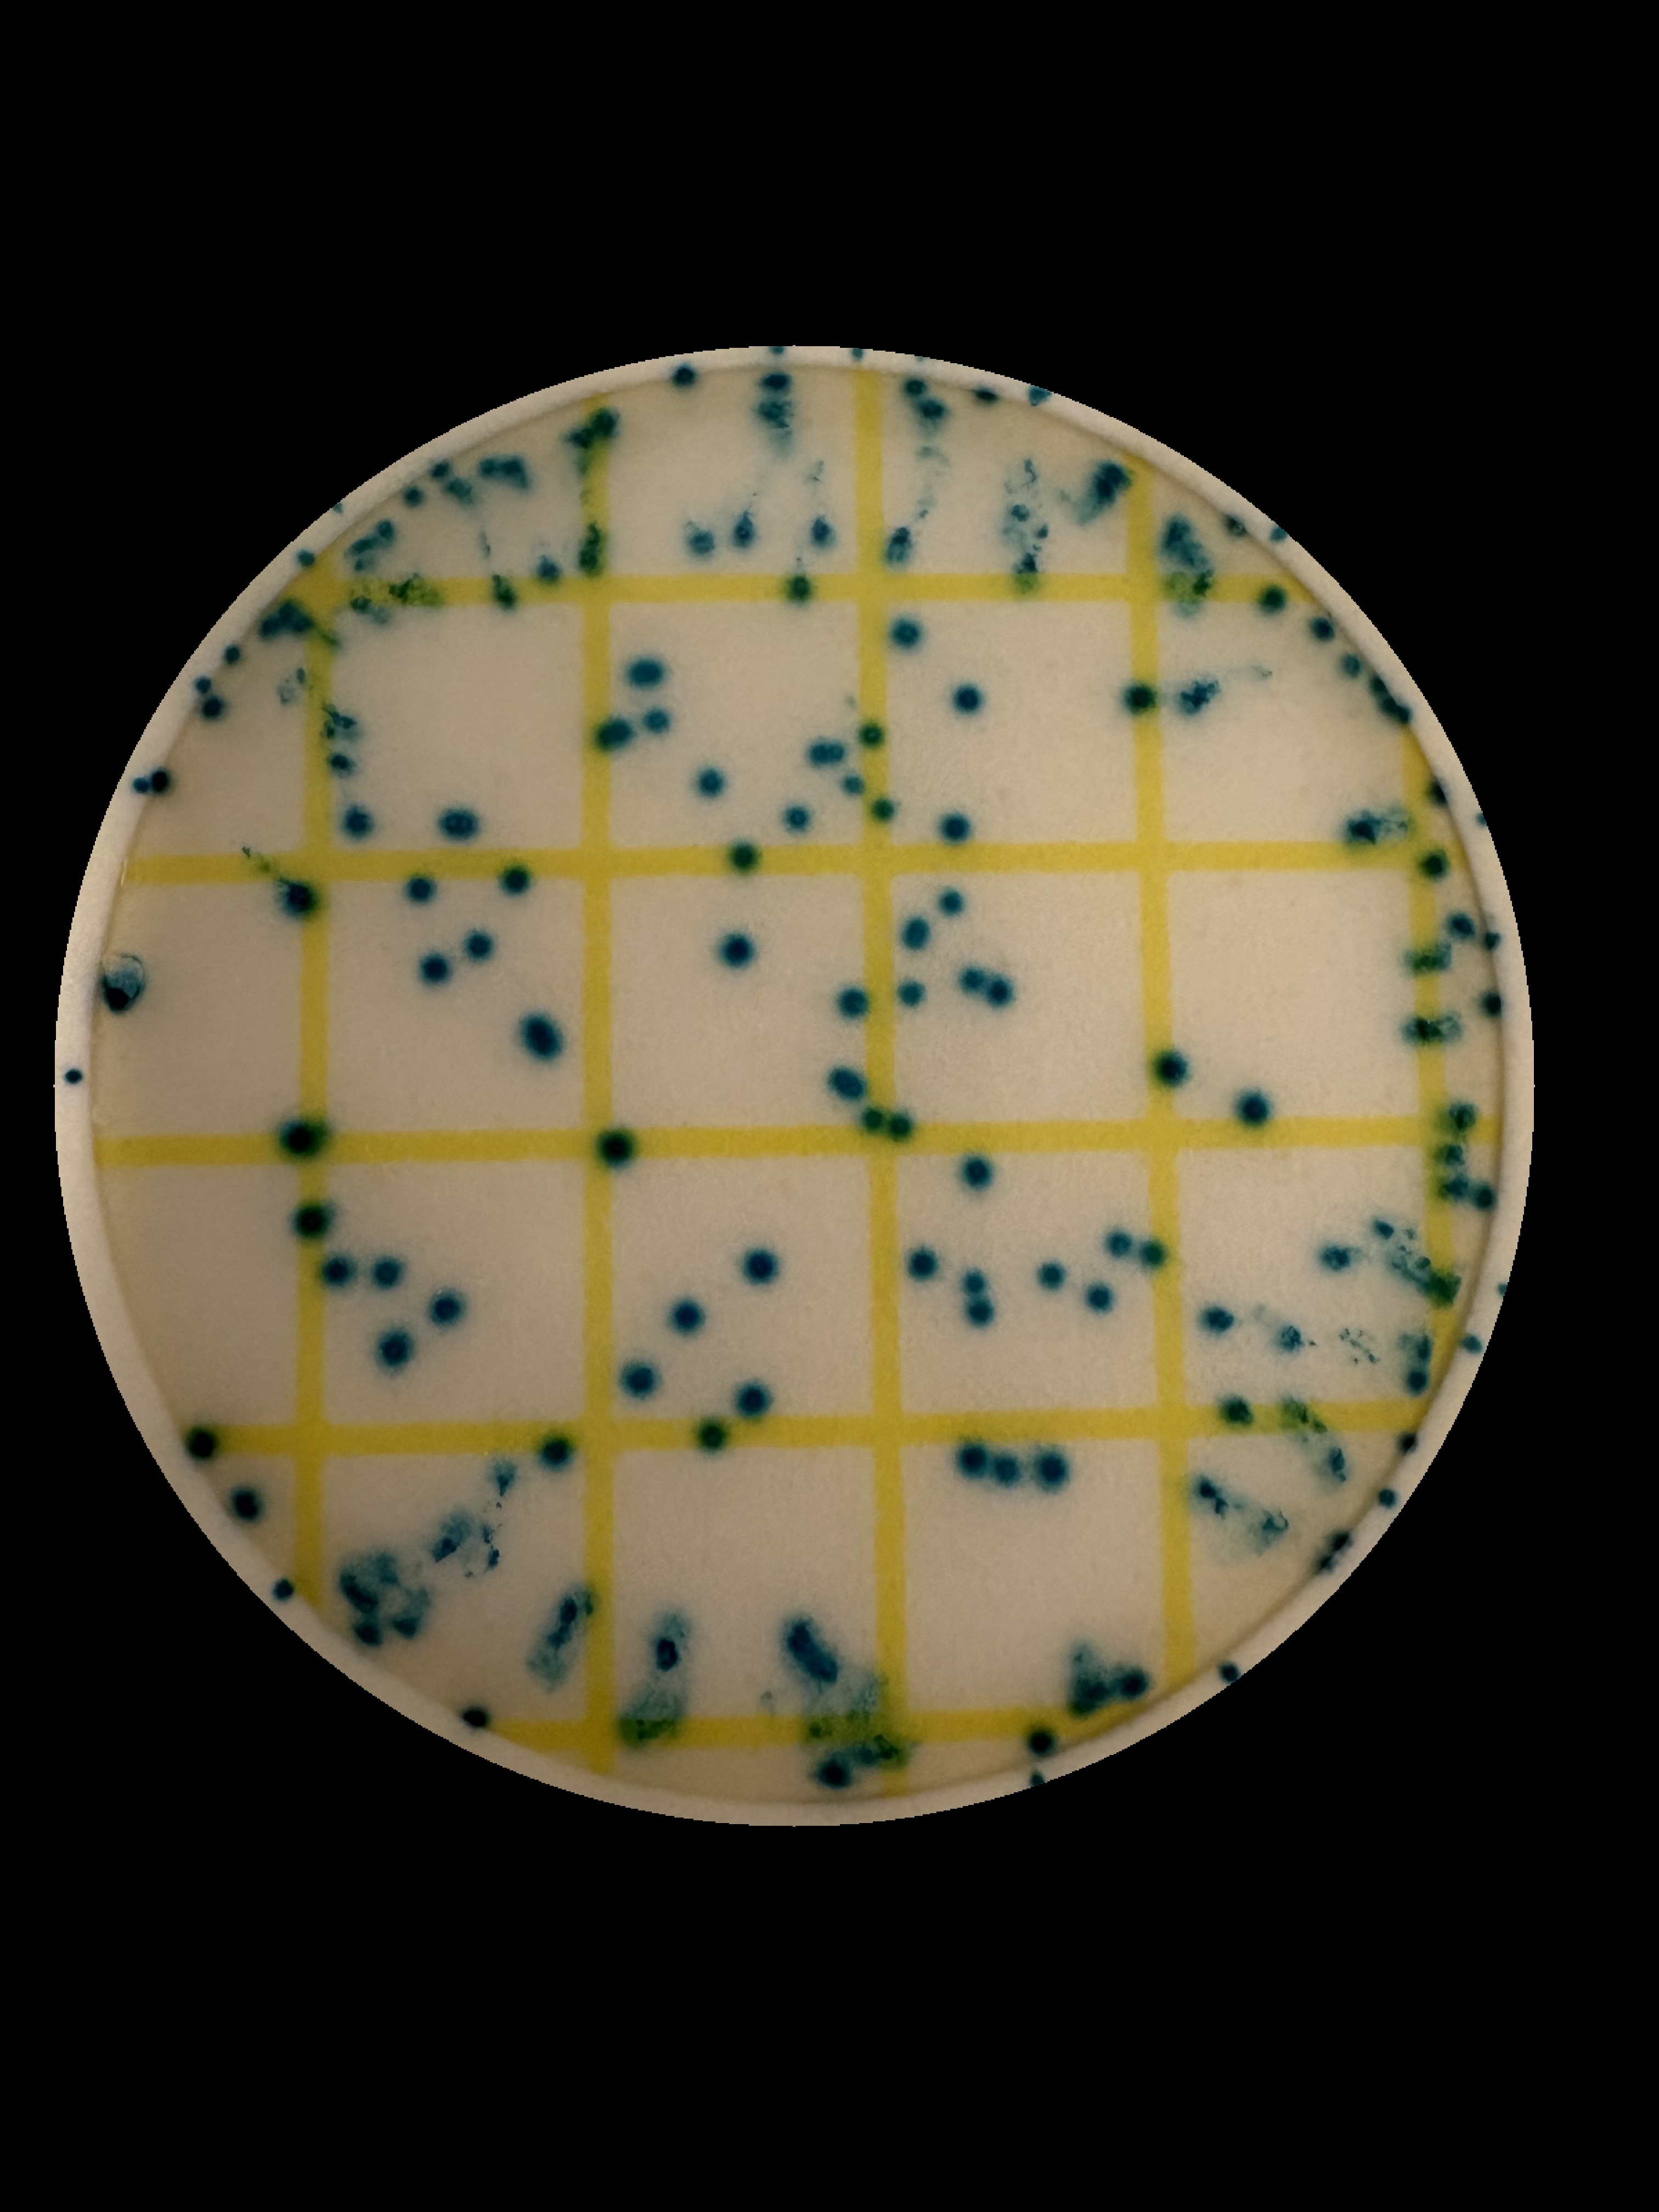
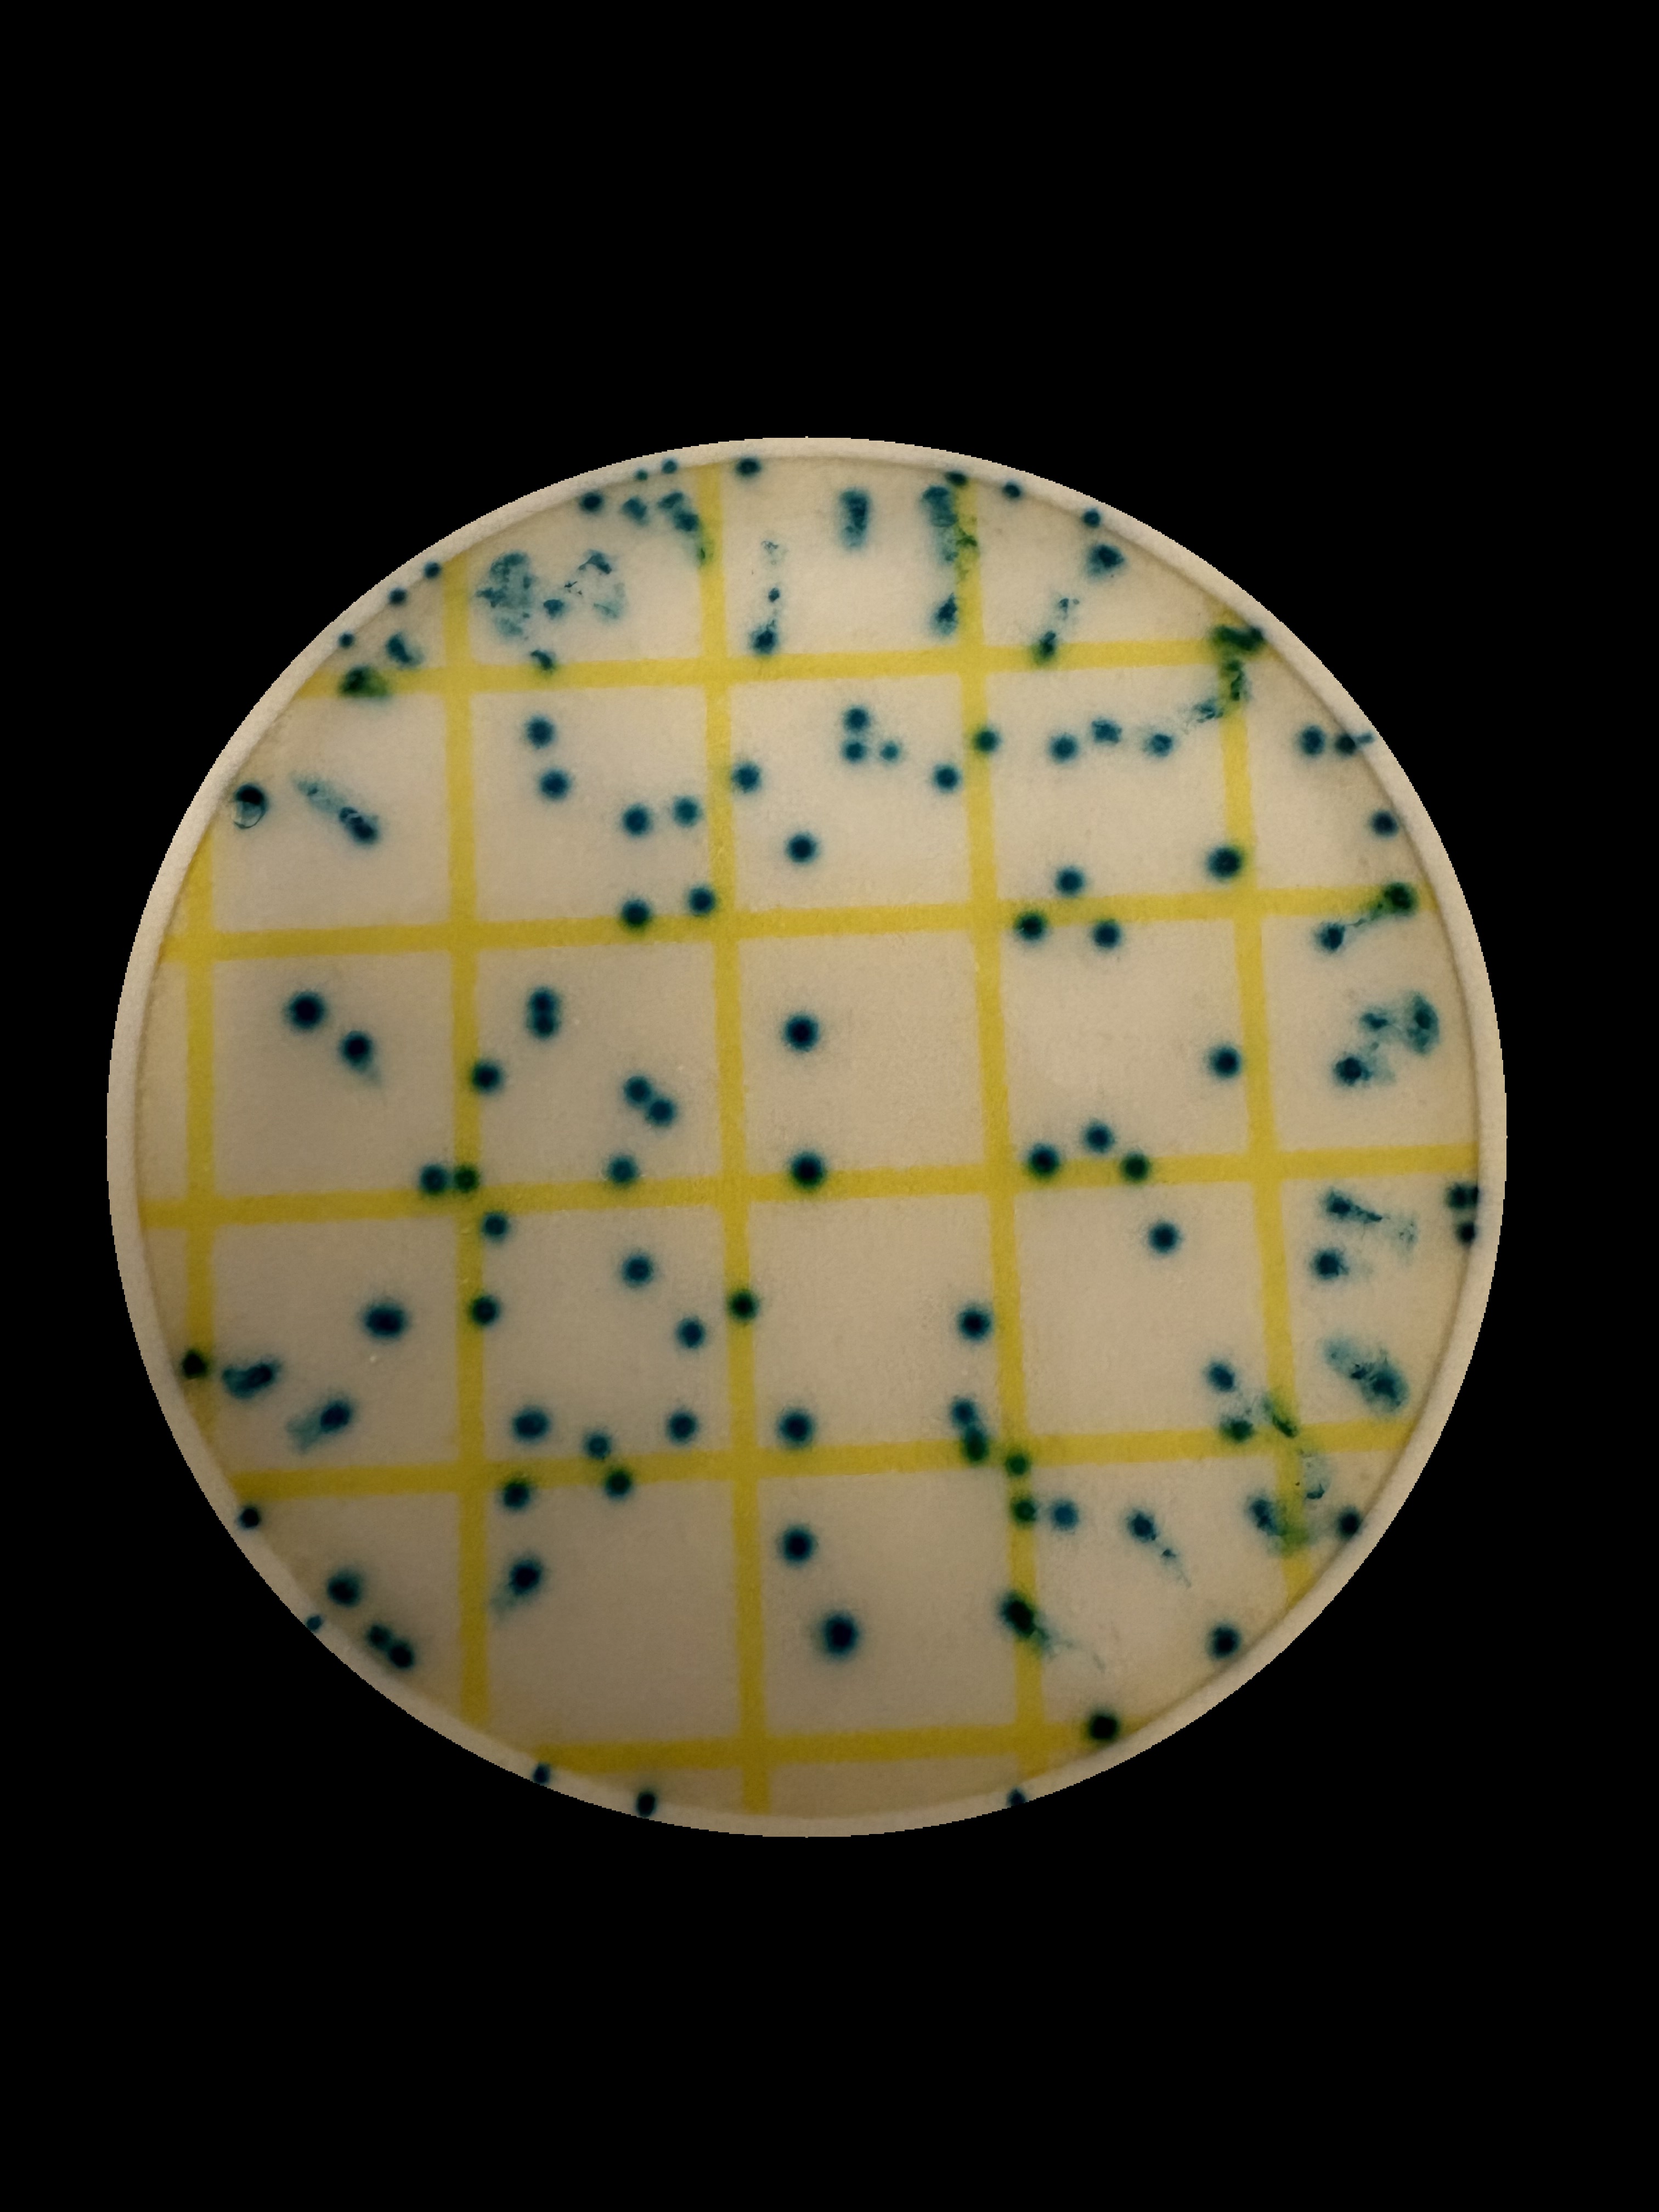
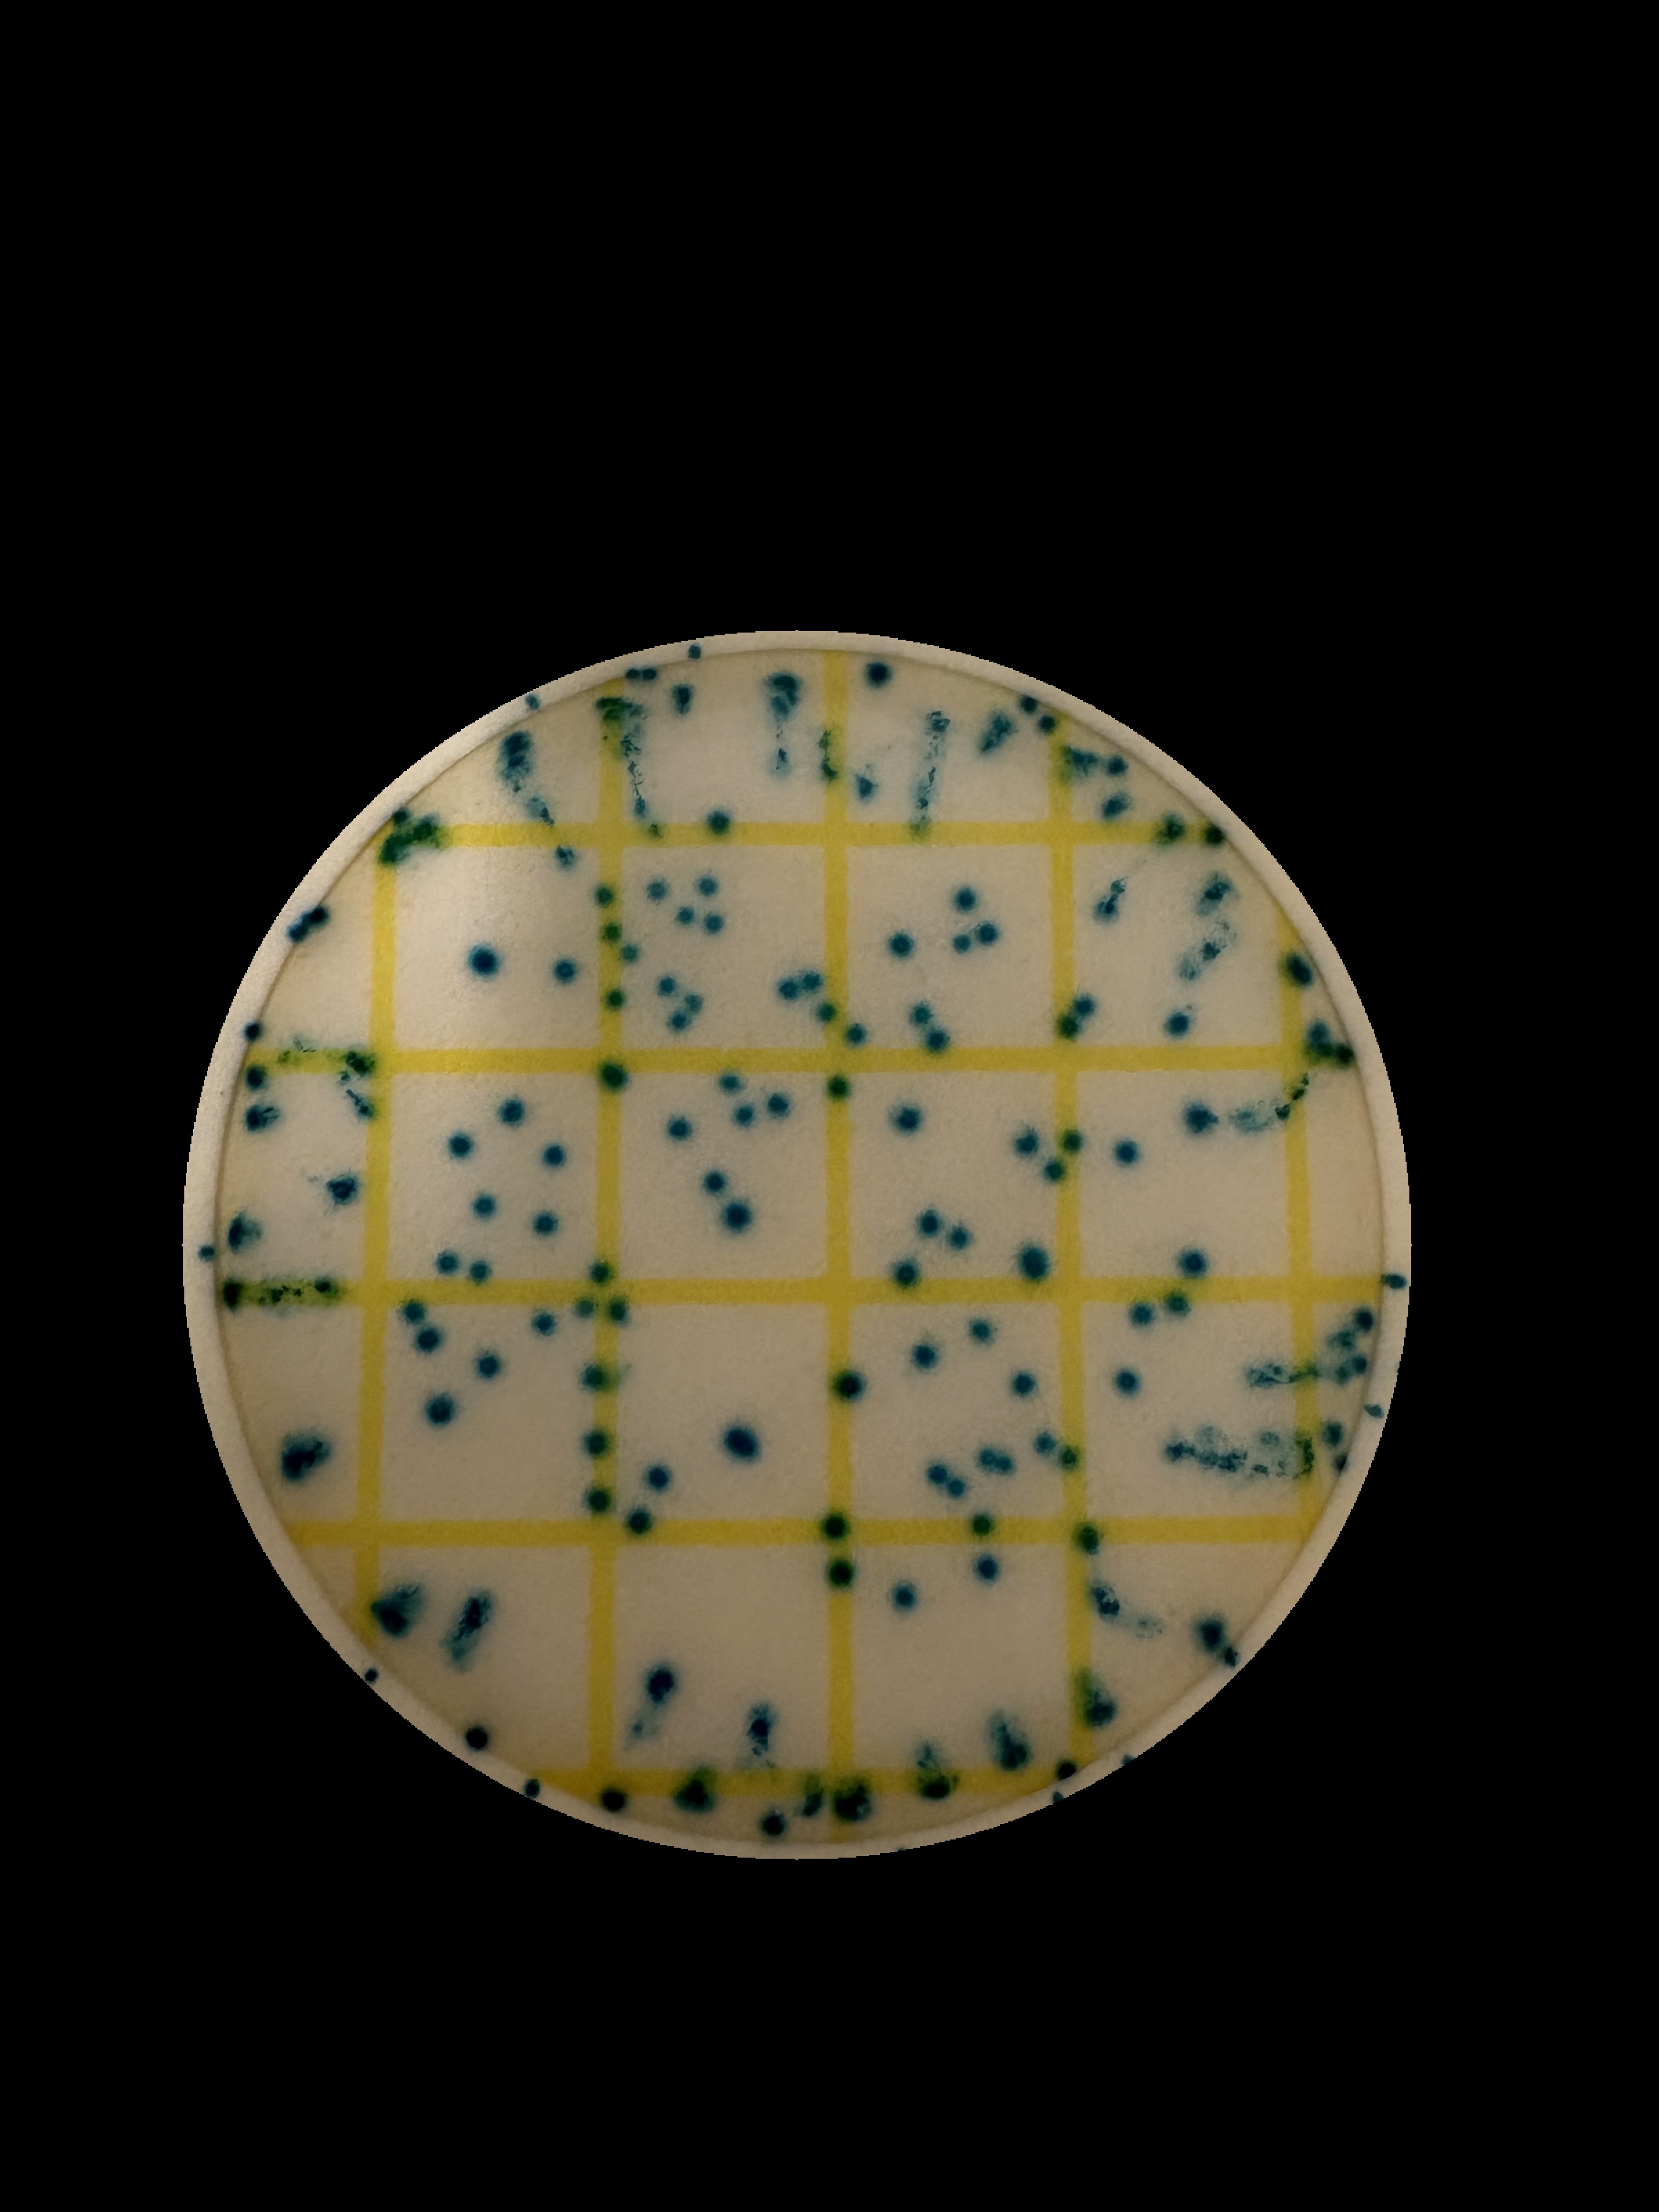
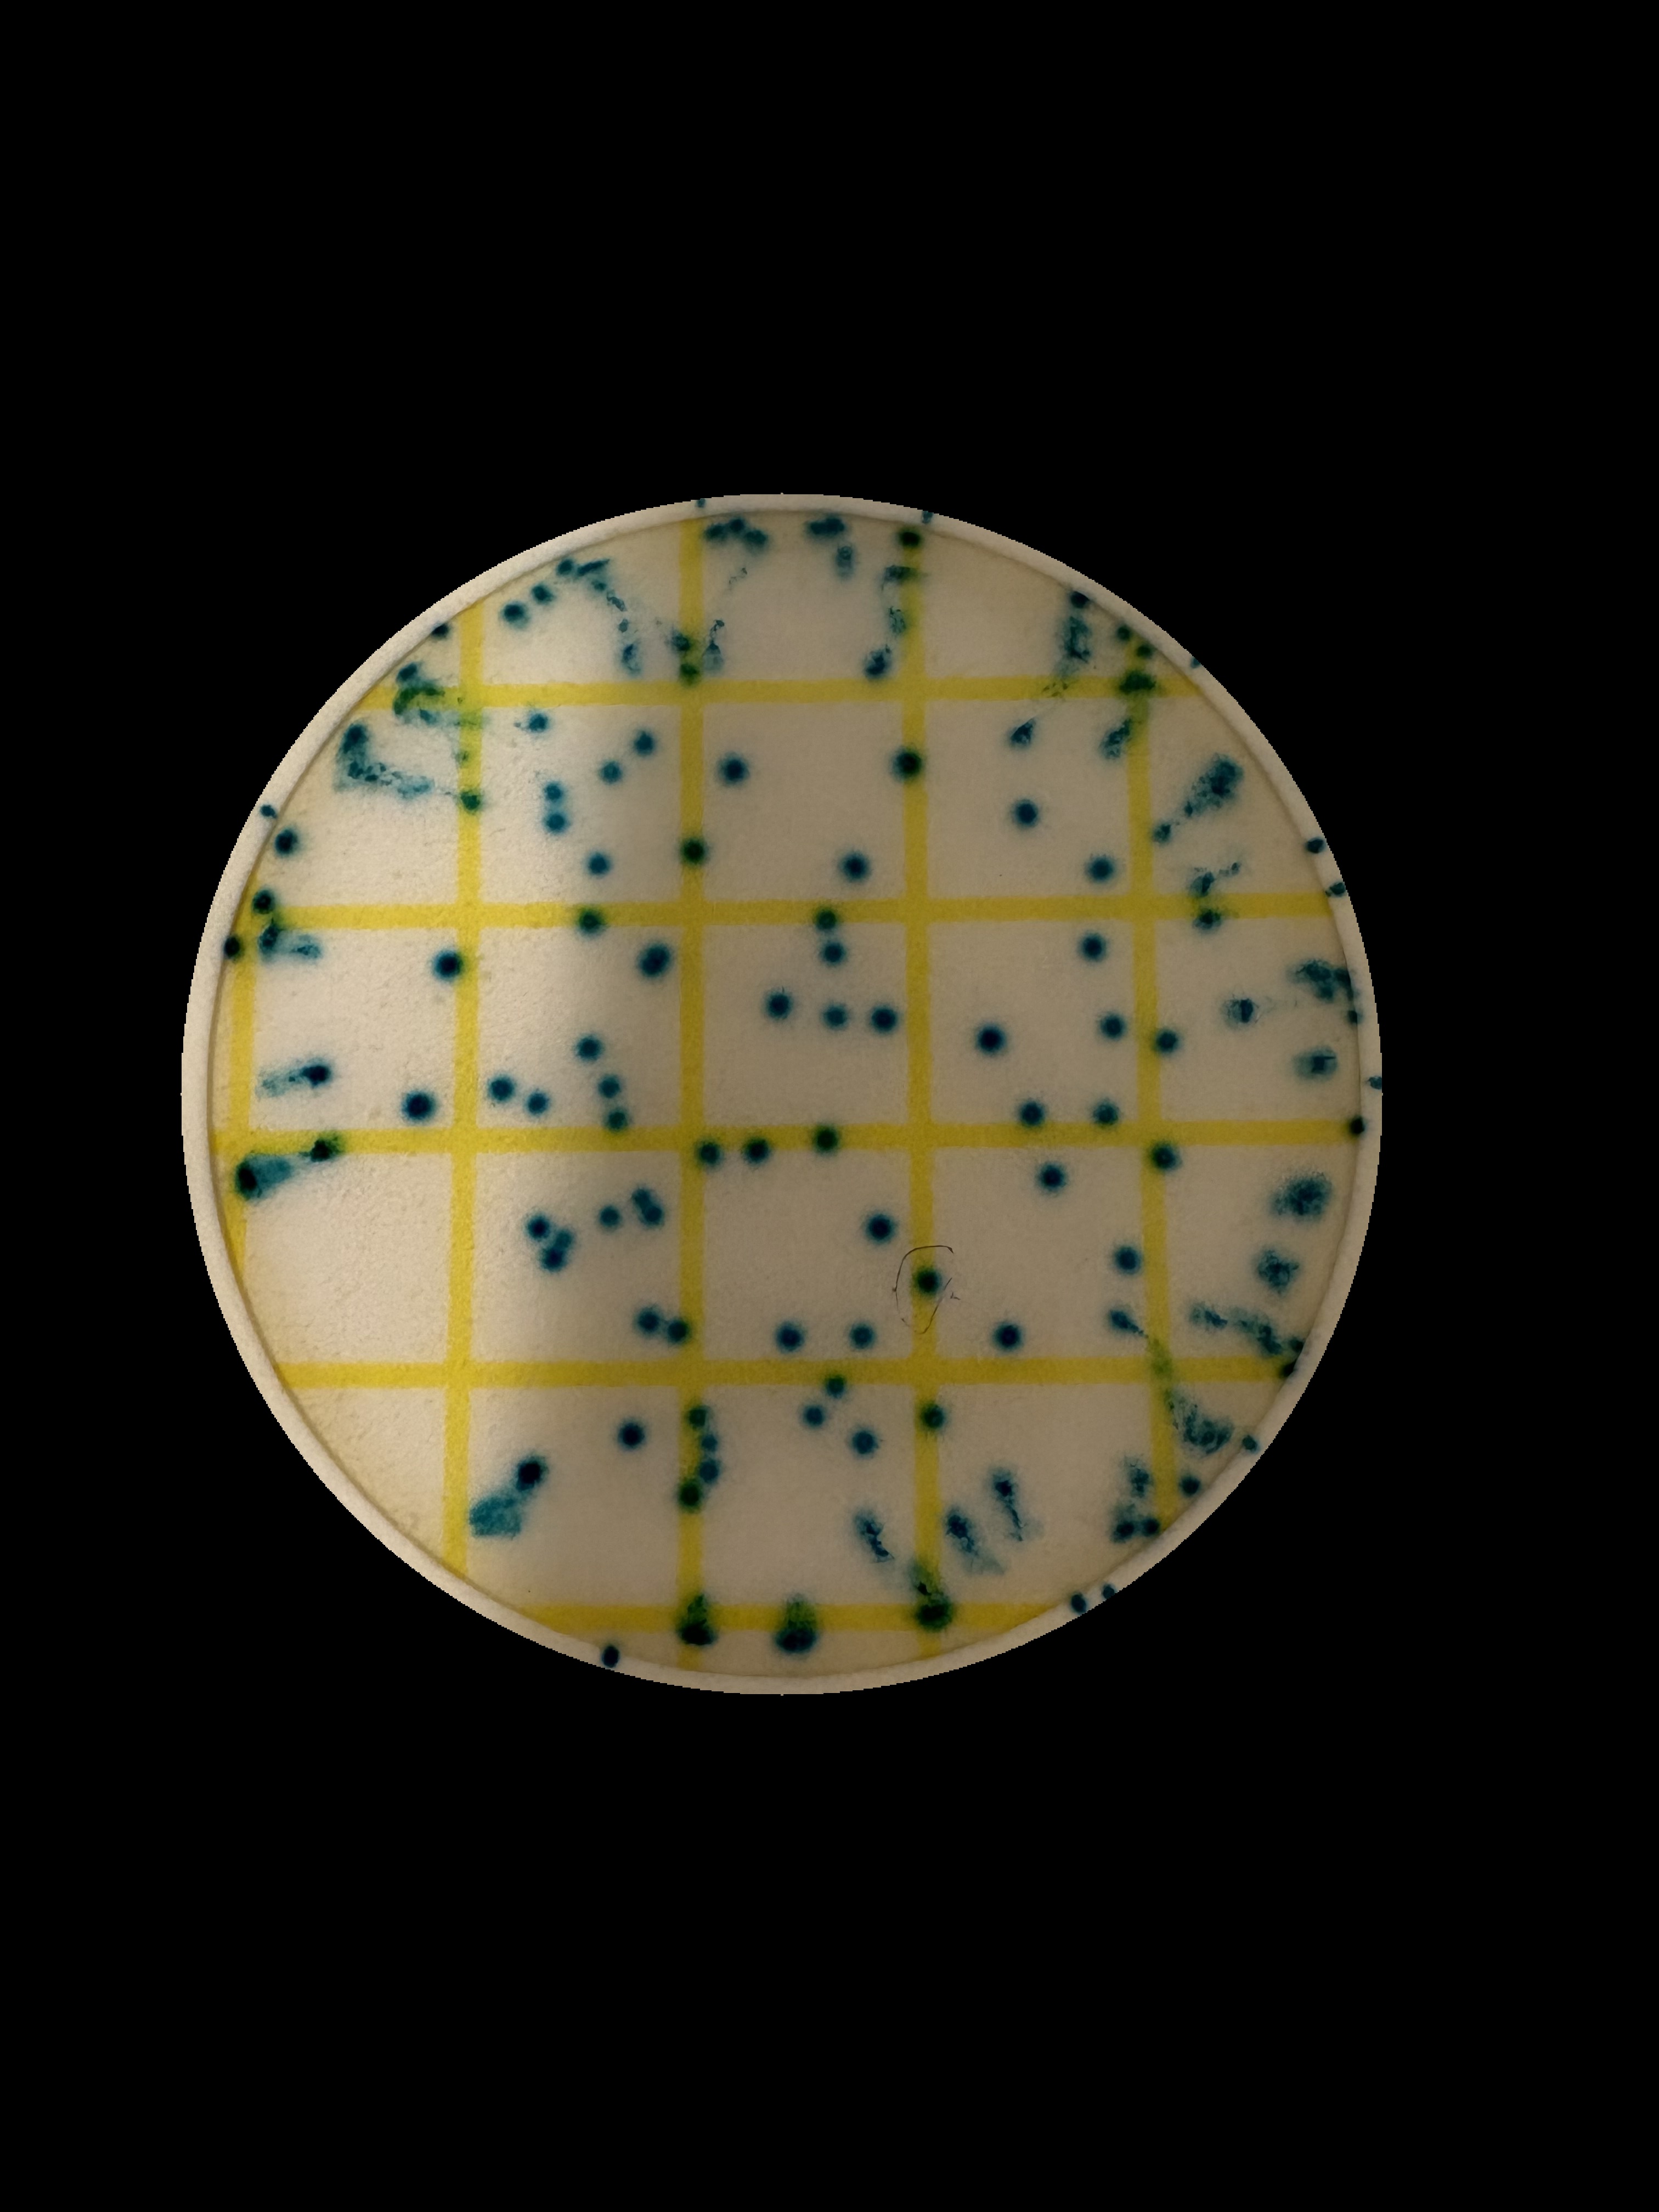
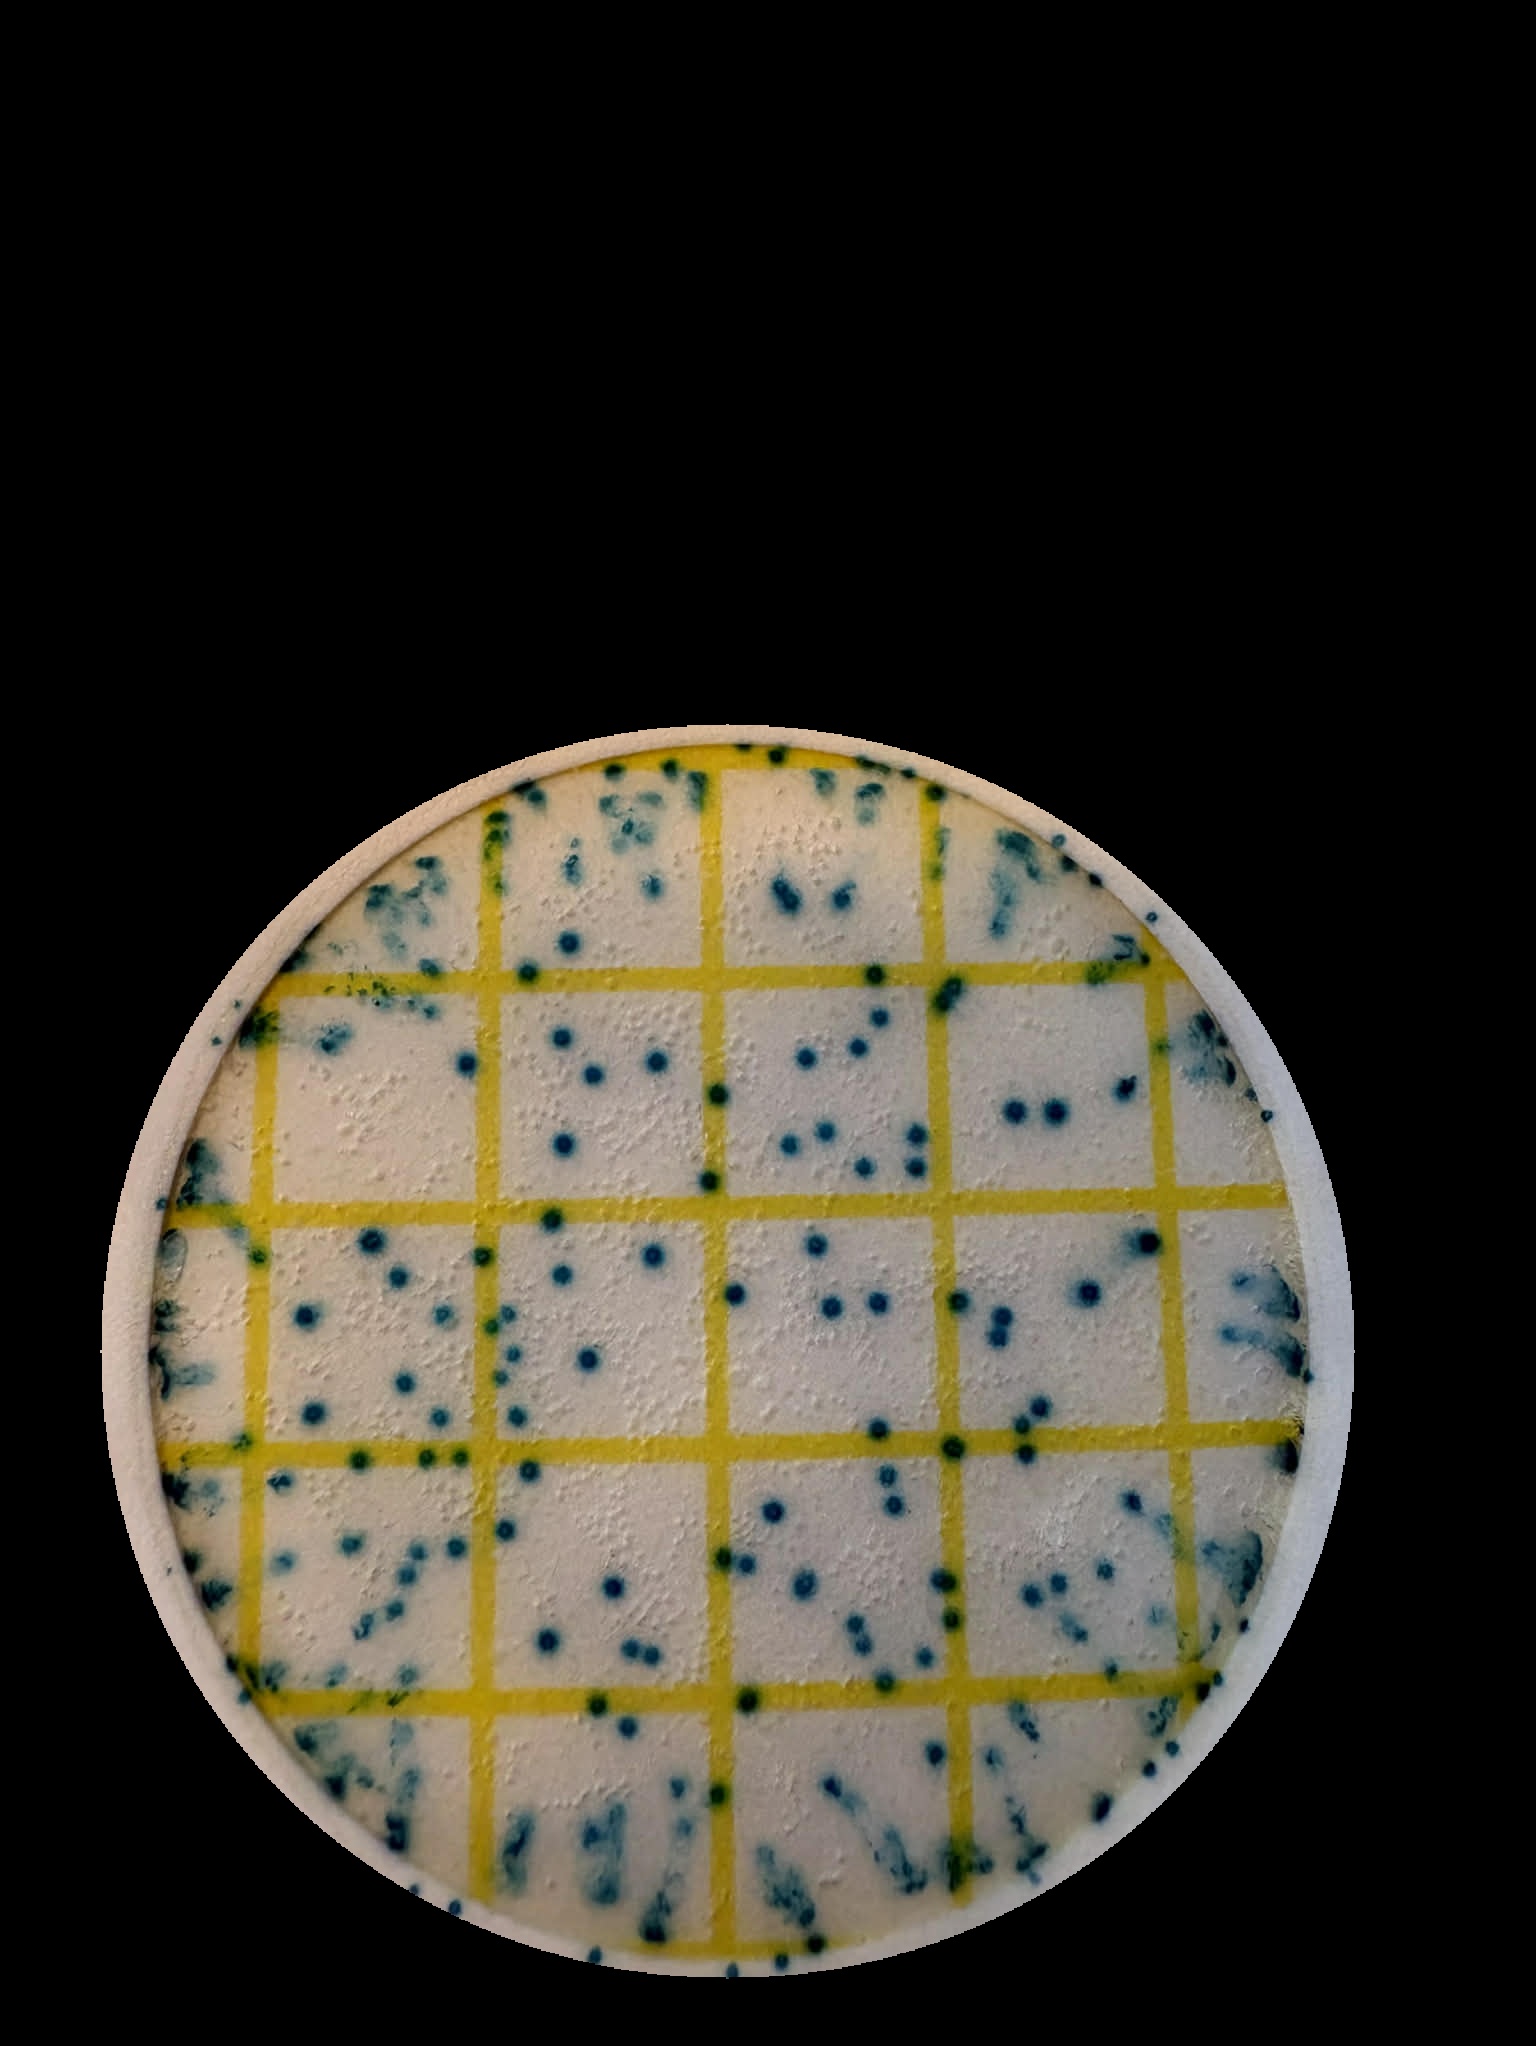
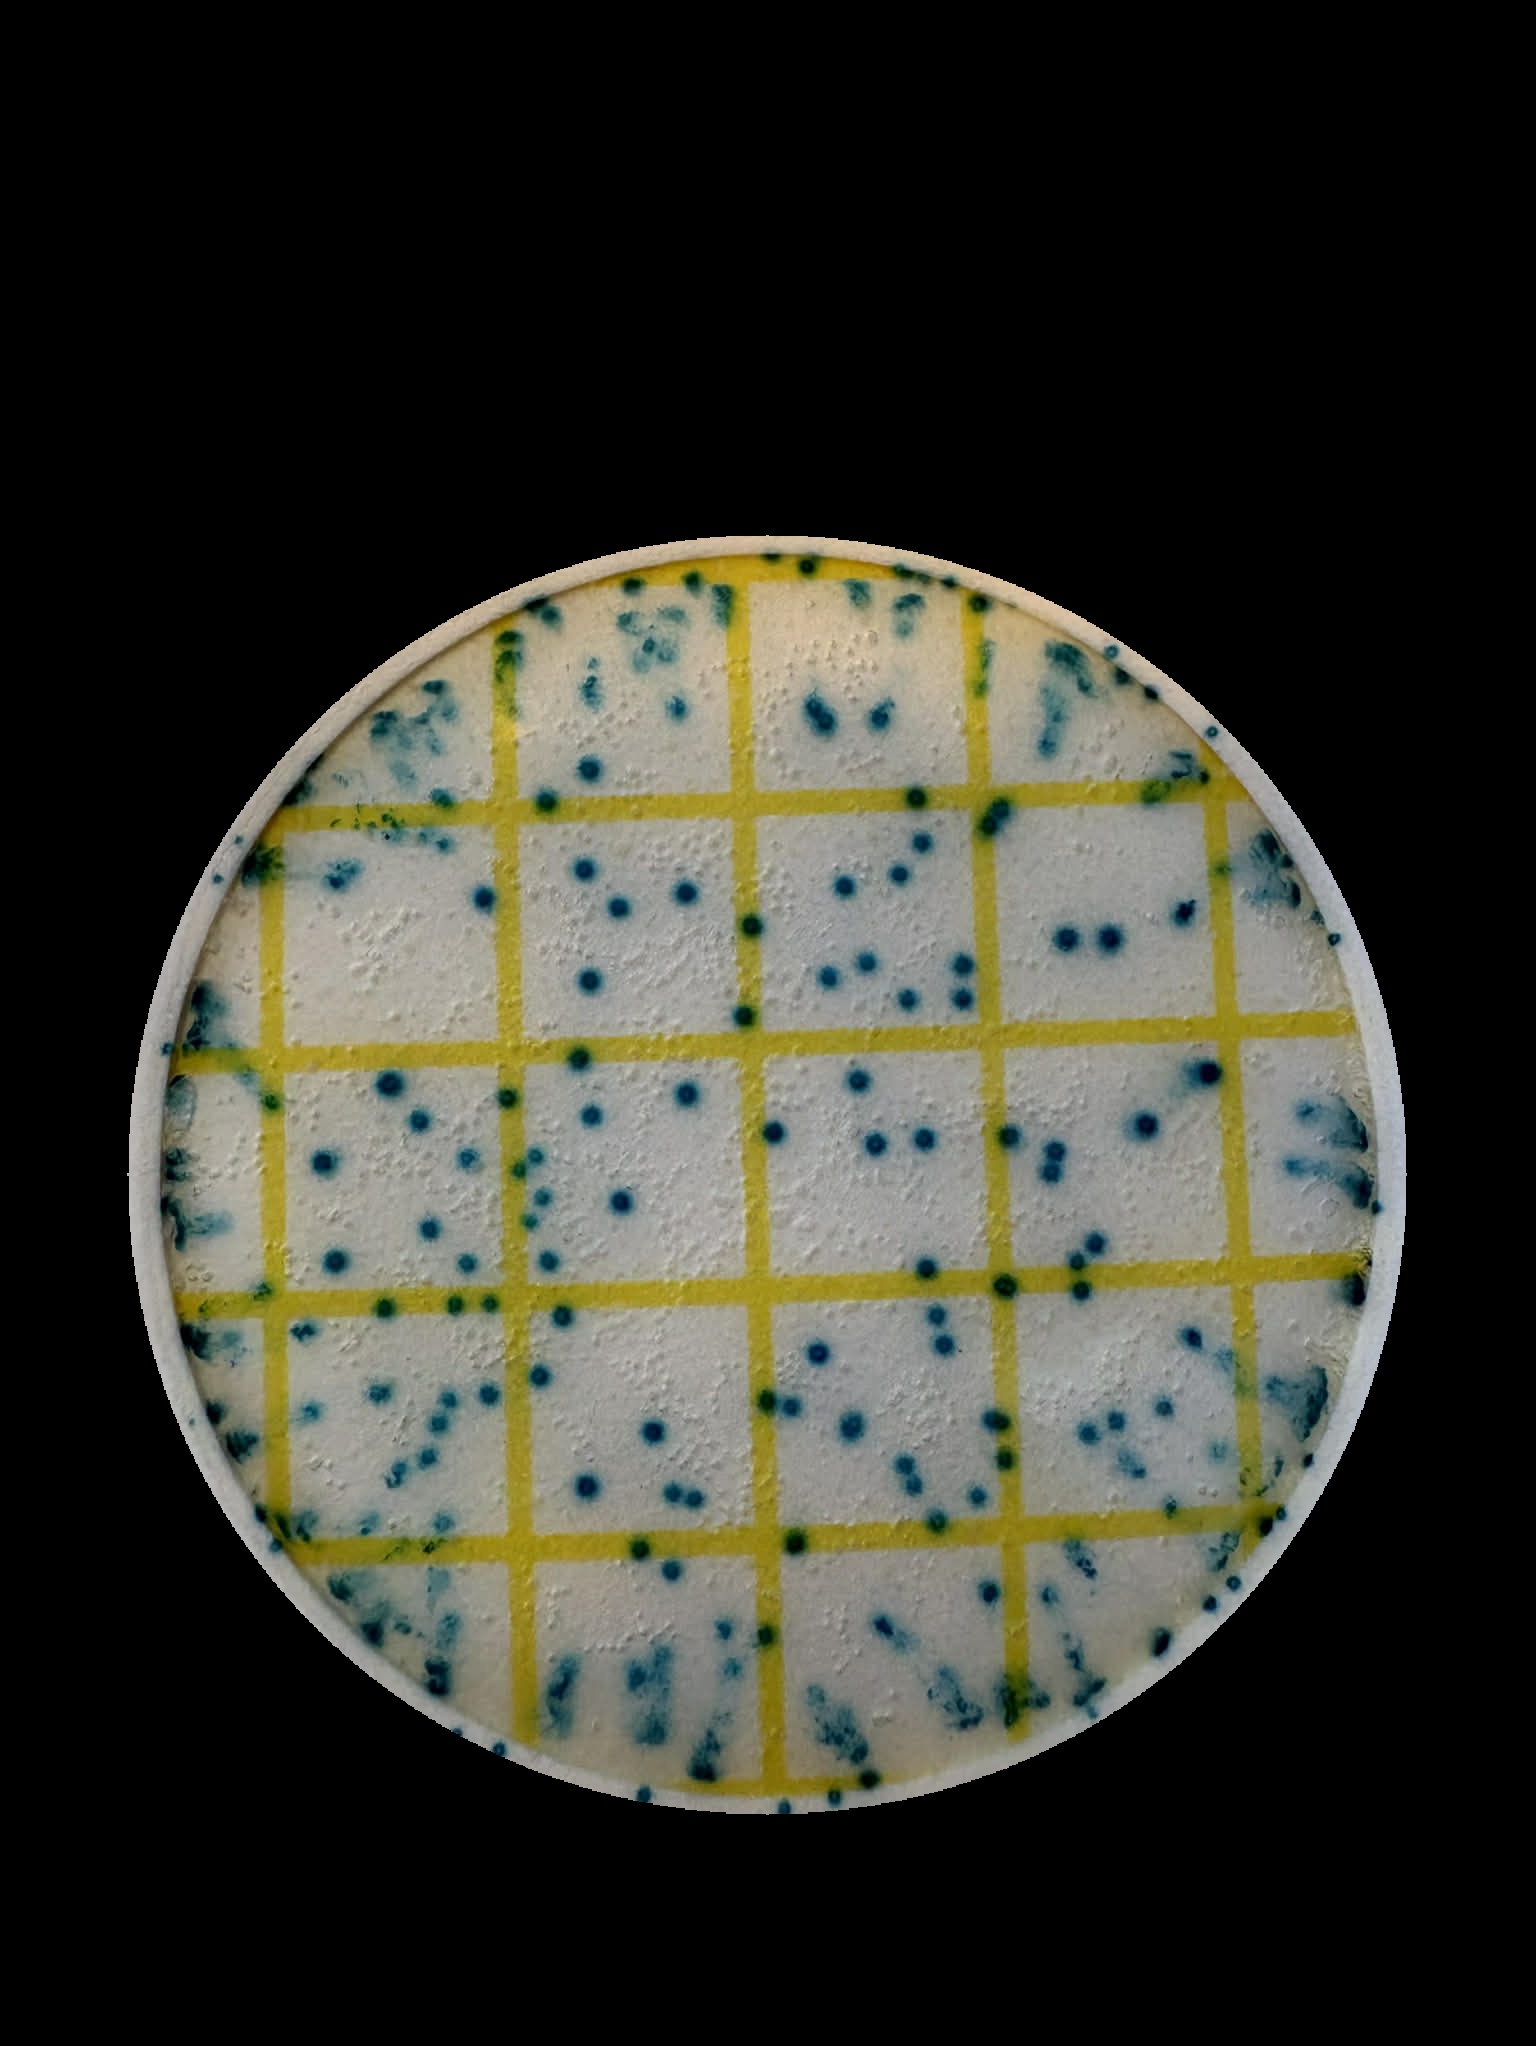

Shop
Discover exclusive offers from your favorite stores. Every purchase earns you reward points that you can use for gifts, discounts, or special deals.
Discover exclusive offers from your favorite stores. Every purchase earns you reward points that you can use for gifts, discounts, or special deals.
When you shop, simply let the store scan your QR code. Instantly collect reward points for your purchase and use them later for discounts, gifts, or exclusive offers.
Every purchase you make earns points. Collect them and use your points to grab exciting rewards, discounts, and exclusive items. The more you shop, the more you can enjoy!
Approximate scale: 380 nm to 750 nm. For real wavelength readings, calibrate with a known light source.
Tap here to scan petrifilm
Find the perfect offer for you!
You can also use you award points to buy shit in the store

65464

567

2000

5555

2000

2000

222

2000

Earn 2000 points for 2 cookies
Earn 100 Points
Earn 100 Points

567

5555

65464

Help train the model using corrected values.